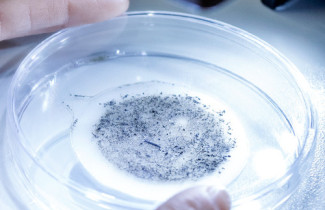
Tutkimusryhmän kuva: Mikromuovien analyysin ja poistomenetelmien kehittäminen teollisuuden laadunvalvontaan (MAP-hanke)

Mikromuoveja löydetään lähes kaikkialta ympäristöstä, ja on todennäköistä, että niihin liittyvä sääntely tulee lähivuosina lisääntymään.
Mikromuovit on jo mainittu tarkkailtavien aineiden listalla EU:n juomavesidirektiivissä. Mikäli mikromuoveista katsotaan aiheutuvan terveyshaittaa, aiheutuu talousvedentuottajille myös seurantavelvoite.
– Sama koskee elintarvikekontaktimateriaaleja. Esimerkiksi elintarvikepakkauksista ei saa siirtyä niiden ainesosia elintarvikkeisiin sellaisia määriä, jotka tekisivät elintarvikkeen ihmisen terveydelle haitalliseksi. Tämän vuoksi yritykset tarvitsevat tietoa mikromuoveista, niiden lähteistä, analytiikasta ja poistomahdollisuuksista, kertoo MAP-hankkeen vastuullinen johtaja, Staff Scientist Laura Tomppo.
– Mikromuovien analysoimiseksi ei ole tällä hetkellä standardoituja menetelmiä. Mikromuovien analyysin ja poistomenetelmien kehittäminen teollisuuden laadunvalvontaan (MAP) -hankkeessa tarkastelimme mikromuoveja teollisuuden näkökulmasta.
Hankkeessa kehitettiin menetelmiä mikromuovien mittaamiseksi vesi- ja elintarvikenäytteistä, sekä erilaisista pakkausmateriaaleista. Kehitetyillä menetelmillä todettiin, että Kuopion alueen talousvesi ja pullotetut kaupalliset vedet ovat mikromuovien suhteen todella puhtaita.
– Mikäli elintarvikkeissa havaitaan mikromuoveja, ne voivat olla peräisin esimerkiksi pakkauksista. Elintarvikepakkauksia olisikin jatkossa syytä tutkia lisää. Tätä voidaan jatkossa tehdä hankkeessa kehitetyillä menetelmillä, iloitsee tutkijatohtori Kaisa Raninen.
Ranisen mukaan muovi on tärkeä materiaali, joka muun muassa mahdollistaa elintarvikkeille pitkän säilyvyyden. Siksi ei ole järkevää kieltää muovien käyttöä kokonaan, vaan olennaista olisi tunnistaa materiaalit, joista on haittaa terveydelle tai ympäristölle. MAP-hankkeessa kehitettiin menetelmiä mikromuovien sisältämien yhdisteiden ja niiden toksisuuden tutkimiseksi. Näitä voidaan hyödyntää jatkossa mikromuovien haitallisuuden arvioinnissa.
MAP-hanketta toteutti Itä-Suomen yliopiston poikkitieteellinen tutkimusryhmä, johon kuului kemistejä, fyysikoita, elintarviketieteilijöitä, ympäristötieteilijöitä ja toksikologeja. Menetelmäkehityksen lisäksi hankkeessa kartoitettiin laajasti tämänhetkistä tutkimustietoa mikromuoveista. Hanke toteutettiin vuosina 2022–2023, ja se sai EAKR-rahoitusta Pohjois-Savon liitosta.
Hankkeen tuloksena on koostettu julkaisu, joka sisältää neljä laajaa kirjallisuuskatsausta mikromuoveista:
Raninen Kaisa, Uurasjärvi Emilia, Peräniemi Sirpa, Soininen Tuomo, Vepsäläinen Jouko, Järvelä Essi, Riekkinen Kati, Karim Shahina, Selenius Mikko, Savolainen Ritva, Visuri Roosa, Koistinen Arto, Tomppo Laura. Mikromuovien analytiikan ja poistomenetelmien kehittäminen teollisuuden laadunvalvontaan. Publications of the University of Eastern Finland. Reports and Studies in Science, Forestry and Technology, 4. 2023. Saatavilla: http://urn.fi/URN:ISBN:978-952-61-4999-8
Lisäksi hankkeen oppeja on koottu videoseminaariksi, joka on katsottavissa sivustolla: https://sites.uef.fi/map-hanke/
Lisätietoja:
MAP-hankkeen vastuullinen johtaja, Staff Scientist Laura Tomppo, [email protected]
Hankkeen tiedot: Mikromuovien analyysin ja poistomenetelmien kehittäminen teollisuuden laadunvalvontaan (MAP-hanke) https://uefconnect.uef.fi/tutkimusryhma/mikromuovien-analyysin-ja-poistomenetelmien-kehittaminen-teollisuuden-laadunvalvontaan-map-hanke/